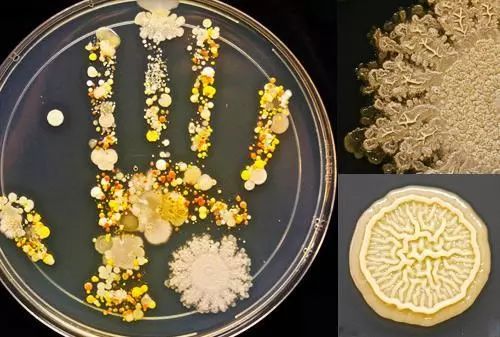
泡腾片洗完还可以用洗衣液吗,为什么泡腾片能用来打扫卫生

勤洗手,是预防疾病传播的重要方式,也是保持健康的良好习惯。
尤其是眼下这个时节,除了出门要戴口罩,勤洗手更显得尤为重要。
一双没洗干净的手,皮肤和指甲里就藏着几十万甚至几百万个细菌。

多通风和勤洗手,做好这两步相当关键,世界卫生组织给出的有关新型冠状病毒的防护建议中,第一条就是洗手。
它是最能有效预防病毒和细菌的方法之一。

「勤洗手」这三个字从小就是很多人的耳边风,被爸妈念叨,被老师念叨,以至于被习惯性忽视,但现在绝不能忽视!
想要好好洗手,也得有好的装备!LARGE泡腾洗手液,随时随地自制1瓶洗手液,高效去菌的同时还能滋润双手。

推荐理由:
1、一颗泡腾片+一瓶清水=洗手液,方便!
2、富含76%芦荟提取物,纯植物提取,不含酒精和有害化学添加剂,没有刺激性。
3、富含芦荟保湿因子和甘油,滋润保湿,连护手霜都省了。
1颗泡腾片+1瓶清水
超方便好用的洗手液
提到泡腾片小编第一反应就是各种各样的维生素,不过这瓶洗手液真是打开了小编新世界的大门。

想要用这瓶洗手液,我们先装一瓶250ml清水再放入一颗泡腾片。

接着就能看到泡腾片在水里咕嘟咕嘟冒泡泡~

等待15分钟,1瓶好用的洗手液就诞生了!

洗手液新奇好玩不重要,重要的是它要有合格的清洁能力。
植物精华,温和清洁
不含有害的化学成分
与市面上许多洗手液不同。LARGE泡腾洗手液是靠植物清洁的,它不含伤手的化学成分的,用明火也无法点燃。

质检报告奉上,大家也会多一份安心。

那这款洗手液是靠什么来洗净双手并消灭细菌的呢?
芦荟
大家都知道芦荟是美容圣品,但消毒杀菌它也是一把好手。

芦荟的抗菌效果来源于Aloin的细胞素功能,这种具有相对进攻性的生化性质,使得芦荟有了去菌的本事。

聚乙二醇
聚乙二醇被广泛应用在隐形眼镜护理液中,因为细菌在有聚乙二醇的环境里难以生长。

检测报告在此,日常的清洁去菌都妥妥的。

而且聚乙二醇兼有很多优良的性质:温和性、润滑性和使皮肤润湿、柔软。

除此之外,无需用水,轻轻按压就可挤出绵密的泡沫。

泡腾洗手液挤出来的泡沫真的绵密细腻,延展性也非常好,洗手都直接变成享受。

那如何正确洗手?
1、用干净的自来水(温水或冷水)打湿,关掉水龙头;
2、用洗手液搓手起泡,一定要在手背、手指间和指甲下涂抹肥皂泡沫;
3、维持至少20秒。

滋润保湿
还你白嫩双手
很多洗手液为了追求清洁力,每次洗完手都会又干又涩,不涂护手霜根本不行。

不过用了泡腾洗手液连护手霜都省了,因为它保湿的效果真的很棒~
用它洗了手之后测一下水油,当真是水水润润。

而且洗手液的酸碱度也是跟我们肌肤更相近的弱酸性,非常温和。

别的不说,用完之后看着自己的手我能再爱自己50年!

而它拥有这么好的保湿滋润效果当然得益于它大手笔地添加了76%芦荟提取物。

芦荟的美容功效大家都清楚,补水、保湿、美白、抗衰老,用在手上真的秒变少女手。
好用便携
妙用非常多
上厕所感到寂寞,是忘带手机的锅。

但手机每平方厘米上有超过12万个细菌,一部手机上有超过上百万个细菌,比马桶垫上的细菌还多。
边上厕所边玩手机,厕所里的细菌,也会粘到手机上,也就是说,上完厕所只洗手是不够的,还得顺便洗一下手机。
所以我就非常奢侈地用泡腾洗手液擦了擦手机。

脏兮兮布满指纹的手机屏幕变得干干净净,最重要的是这样一个被细菌侵占的区域被清洁好,玩手机更安心啦。
还有每天被我们摸了无数次的键盘,也可以用泡腾洗手液来消个毒。

而且小小一瓶,放在洗手间也是很有格调的。

放在工位上,吃完零食之后洗干净黏糊糊的手指才能继续好好摸鱼工作(懒癌发作的时候也可以当免洗洗手液用)。

它配有一个锁扣,可以防止不小心按压。

所以放在包包里也没有问题,这样出门在外也能随时随地保持卫生,防止病毒的流通。

如果带孩子出门弄脏了手,室外又找不到水龙头,包里装瓶它,先稍作清洁,到了有水源的地方再彻底清洗!

而且LARGE还通过了国际认证联盟IQ NET和CQC质量安全体系认证。
2017年更是与美国亚太区多家国内外知名企业达成合作关系。是真正让人信赖的大品牌。

一套洗手液配有1个起泡瓶和10颗泡腾片。可以自制10瓶洗手液,非常划算。

旗舰店的价格是69.9元。

我们限时特惠,只卖59元!

【自制洗手液 洁净又卫生】LARGE泡腾洗手液
¥59
购买